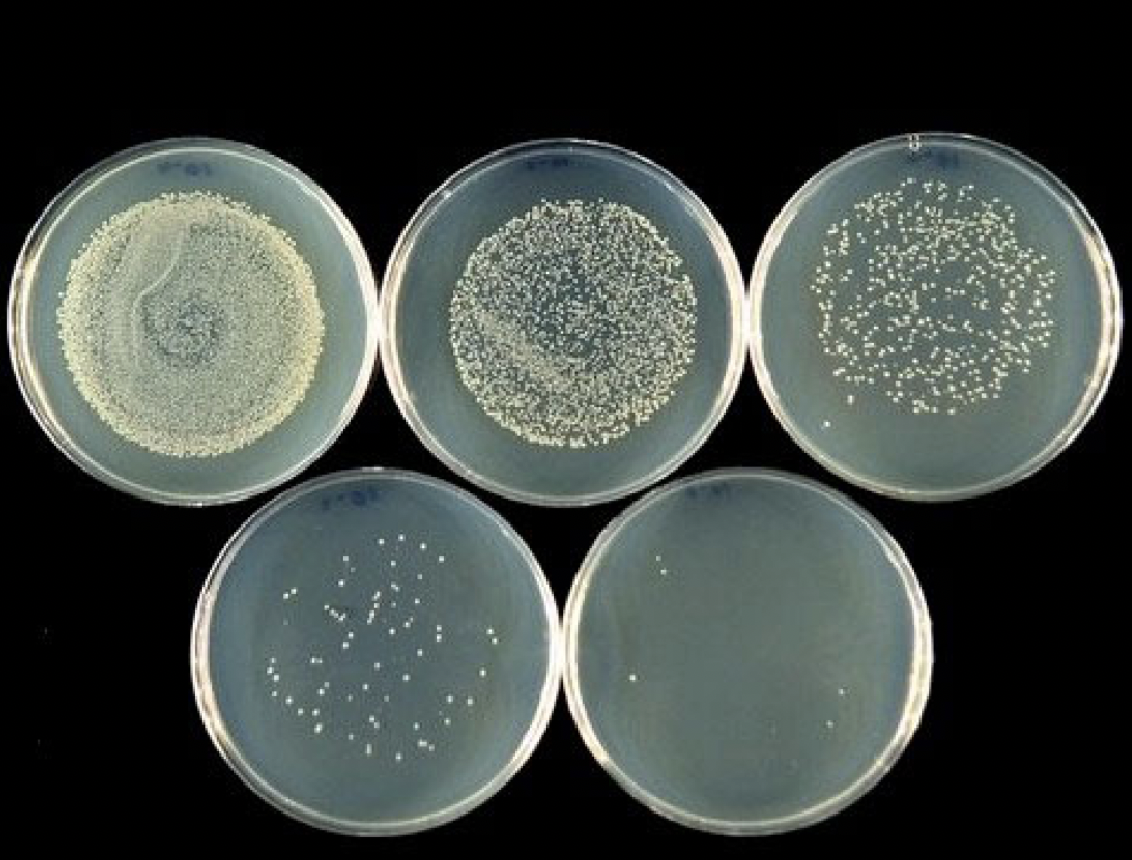
<p>What method of dilution involves a small amount of liquid containing microorganisms being spread out over the surface of a plate with a bent glass rod, called a “Hockey Stick.”</p>
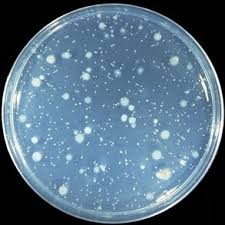
<p>What method of dilution involves diluted cells being mixed with molten agar while it is still warm and then being poured into a petri plate to grow bacterial "lawns”?</p>
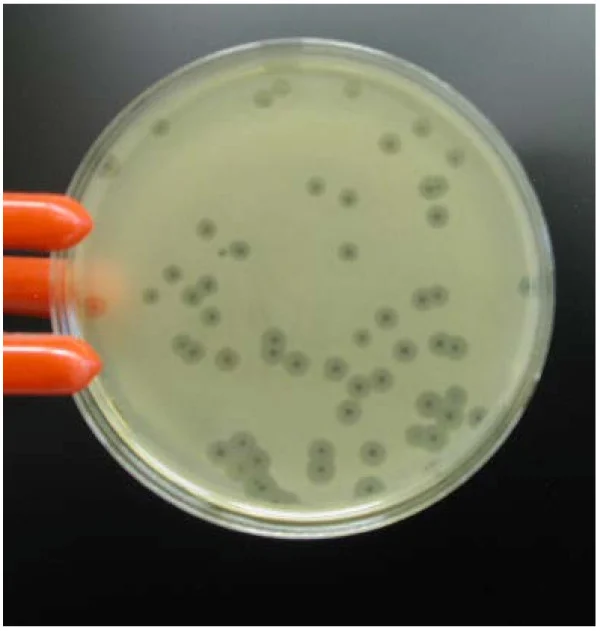
<p>When a bacteriophage lyses an area of bacteria on an agar plate, you see a visible clear patch in the agar’s bacterial _____ called a _______.</p>

Microbiology Lab Final
1/89
Earn XP
Description and Tags
Based on Exercises & Reports
Name | Mastery | Learn | Test | Matching | Spaced | Call with Kai |
|---|
No analytics yet
Send a link to your students to track their progress
90 Terms
What specific type of microscope did we use in lab?
Compound Brightfield Microscope

What part of the microscope is labeled A?
Base

What part of the microscope is labeled B?
Stage

What part of the microscope is labeled C?
Arm

What part of the microscope is labeled D?
Body Tube

What part of the microscope is labeled E?
Condenser

What part of the microscope is labeled F?
Objective Lenses
The _____ _________ is an adjustable opening that controls the amount of light that exits the condenser of the microscope and enters the sample.
Iris diaphragm
What is another name for the eyepiece of the microscope?
Ocular Lenses
The ________ adjustment knob raises and lowers the stage in large amounts to focus the specimen and the ________ adjustment knob raises and lowers the stage in small amounts to focus the specimen.
Course; fine
Most microscopes are __________, meaning that when one lens is in focus all the other lenses will be in focus with only minor adjustment of the fine focus.
Parfocal
__________ __________, or "optical resolution", is the ability of a lens system to distinguish between two neighboring points as separate and distinct.
Resolving Power
What is the range that the light on the microscope should be set to?
4-6
What is the magnification of the scanning objective lens?
4x
What is the magnification of the low power objective lens?
10x
What is the magnification of the high-dry objective lens?
40x
What is the magnification of the oil immersion objective lens?
100x
What is the magnification of the ocular lenses?
10x
What is the total magnification when you are observing a specimen on high-dry power?
400x
__________ _________ is purposeful & directional swimming movement exhibited by some organisms.
True Motility
_____________ _________ is the erratic vibration of a particle used for movement caused by the unequal collision of water molecules against it.
Brownian Motion
______________ is a type of movement where all the objects “flow” with the movement of the water.
Streaming
What is the term for the shape of bacteria?
Morphology

What is the morphology of this bacterium?
Coccus

What is the morphology of this bacterium?
Bacillus

What is the morphology of this bacterium?
Spirillum
What bacterial arrangement is characterized by one bacterial cell connected to no others?
Single
What bacterial arrangement prefix is characterized by two bacterial cells connected to each other?
Diplo-
What bacterial arrangement prefix is characterized by a string of bacterial cells connected to each other?
Strepto-
What bacterial arrangement prefix is characterized by a group of bacterial cells connected to each other?
Staphylo-
How would you name a bacterium that has a circular shape and is arranged in a large clump?
Staphylococcus
The _______ ________ transmits the magnified image on a microscope to the ocular lenses.
Body Tube
The ________________ of the microscope contains several sets of lenses that concentrate the light from the light source on to the specimen.
Condenser
What type of stain uses one reagent that stains all bacteria the same way?
Simple Stain
What type of stain uses a simple stain to stain the cell itself?
Direct Stain
What type of stain uses a simple stain to stain the surroundings rather than the bacterium?
Negative Stain
Most direct stains have a _________ charge at normal pH values and therefore tend to stick to the negatively charged bacteria.
Positive
Most negative stains have a _________ charge at normal pH values and therefore tend to be repelled from the negatively charged bacteria.
Negative
What type of stain typically uses multiple reagents, to which different bacteria may react differently in order to differentiate them from another within one sample?
Differential Stain
The Gram stain was developed by __________________ in ____.
Hans Christian Gram; 1884
A __________ is used in staining to intensify color and anchor dyes to microorganisms, preventing them from washing away.
Mordant
What is the primary stain in a Gram stain?
Crystal Violet
What is the mordant in a Gram stain?
Gram’s Iodine
What is the decolorizing agent in a Gram stain?
Ethanol
What is the counterstain in a Gram stain?
Safranin
Gram ________ bacteria have thick peptidoglycan and teichoic acid cell walls and Gram ________ bacteria have thin cell walls with only peptidoglycan.
Positive; negative
What color are Gram-positive bacterial cells after a Gram stain?
Purple
What color are Gram-negative bacterial cells after a Gram stain?
Pink

Is this bacterium gram-positive or gram-negative?
Gram Negative

Is this bacterium gram-positive or gram-negative?
Gram Positive
Microorganisms are said to be ___________, meaning they seem to be present everywhere, including the air we breathe, the water we drink, the food we eat, on our body surfaces, and even inside our bodies.
Ubiquitous
The production of many cells in a liquid causes it to appear cloudy or ________.
Turbid
The production of many cells through multiplication on a flat surface may form a visible clump called a __________.
Colony

What method of dilution involves drawing the microorganisms back and forth across the surface of a solid medium with a wire loop?
Streak Plate
What method of dilution involves a small amount of liquid containing microorganisms being spread out over the surface of a plate with a bent glass rod, called a “Hockey Stick.”
Spread Plate
What method of dilution involves diluted cells being mixed with molten agar while it is still warm and then being poured into a petri plate to grow bacterial "lawns”?
Pour Plate
______________ ______ are generally used to test bacterial motility, since the cells can penetrate and “swim” through the soft medium.
Semi-solid Media
What is a TTC tube used to test for?
Motility
When a bacteriophage lyses an area of bacteria on an agar plate, you see a visible clear patch in the agar’s bacterial _____ called a _______.
Lawn; plaque
What does TTC stand for?
Triphenyl Tetrazolium Chloride

In an inoculated TTC tube, “fuzziness” or “feathering”, especially away from the line of inoculation, would indicate ________.
Motility
What should a sterile nutrient broth tube look like?
Clear
What should a sterile nutrient agar plate look like?
Clean with no breaks, lines, or colors
What dilution method(s) are useful in calculating bacteria per milliliter in the original culture?
Spread Plating and Pour Plating
How many bacteria were in the original bacterial culture if you have a 10-4 plate with 68 colonies on it?
6.8 × 105 bacteria/ml
Heat fixing a slide before staining it __________ the bacteria to the slide.
Adheres
Immediately following the ethanol decolorization step, how would a Gram-positive bacterium appear under the microscope?
Purple
Immediately following the ethanol decolorization step, how would a Gram-negative bacterium appear under the microscope?
Invisible/Clear
The most important step of a differential stain is the __________. This allows different bacteria to be different colors and makes it easier for the viewer to see the difference between them.
Counterstain/Reagent
___________ is the general term for all the chemical reactions that occur within living organisms.
Metabolism
An __________ ___________ is established by putting an oxygen-reducing agent in a medium.
Oxygen Gradient
What is the reducing agent that is used to test a bacterium’s tolerance for oxygen?
Thioglycolate
A thick blue layer in an inoculated THIO tube indicate’s that the bacterium is ______ tolerant to oxygen.
Less
A thin blue layer in an inoculated THIO tube indicate’s that the bacterium is ______ tolerant to oxygen.
More

Bacteria that are _______ _______ require oxygen to grow. So they will only grow at the top of the broth.
Obligate Aerobes

Bacteria that are _______ _______ can only survive without oxygen because oxygen kills them. So they will only grow at the bottom of the tube.
Obligate Anaerobes

Bacteria that are _________ _________ can grow with OR without oxygen, but they grow better with oxygen. So they will grow throughout the entire tube, with heavier growth in the oxygen layer.
Facultative Anaerobes

Bacteria that are _______________ require a SMALL amount of oxygen for growth and will only grow at the bottom of the blue layer.
Microaerophiles

Bacteria that are __________ can grow with or without oxygen. So they have even growth throughout the entire tube. The blue layer will always be there.
Aerotolerant
Sugar fermentation is most easily detected by the production of ______.
Acids
What type of media is used to test sugar fermentation?
Phenol Sugar Tubes
The media used to test sugar fermentation contains a high concentration of test sugar, so if the bacterium can ferment this sugar, it will continue to grow and produce acidic end products causing the pH to _____.
Drop